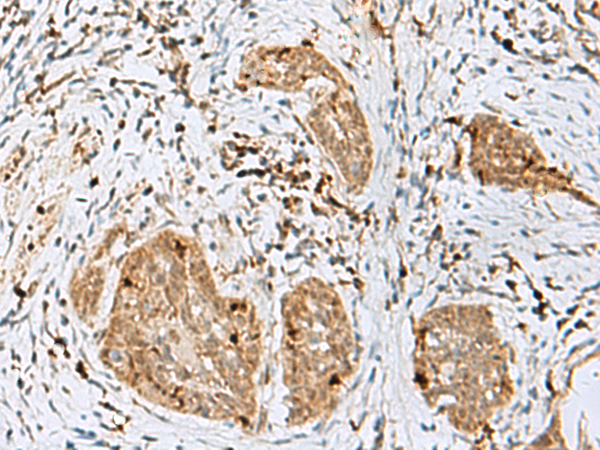

|
Background: |
This gene is X-linked and is expressed in only male germ cells. Two alternatively spliced transcript variants encoding distinct isoforms have been found for this gene. |
|
Applications: |
ELISA, IHC |
|
Name of antibody: |
TEX11 |
|
Immunogen: |
Fusion protein of human TEX11 |
|
Full name: |
testis expressed 11 |
|
Synonyms: |
TGC1; TSGA3; SPGFX2 |
|
SwissProt: |
Q8IYF3 |
|
ELISA Recommended dilution: |
5000-10000 |
|
IHC positive control: |
Human tonsil and Human esophagus cancer |
|
IHC Recommend dilution: |
50-300 |
購(gòu)物車(chē)
幫助
021-54845833/15800441009
